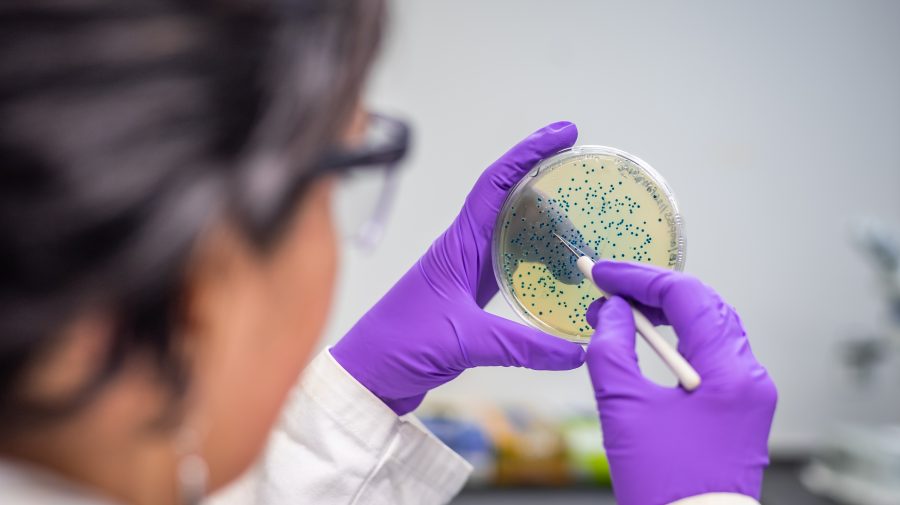
Joburi de viitor: (73) Terraforming Microbiologist

Odată cu succesele recente în călătoriile spațiale, noțiuni de a locui pe alte planete, în special Marte, a devenit mai degrabă o realitate decât un vis.
Terraforming Microbiologist: Responsabilități
În timp ce este posibil să se construiască stații spațiale care au spații locuibile în interiorul lor, oamenii încă nu poate ieși afară fără un costum spațial.
În viitor, Terraforming Microbiologists va lucra ca parte a marilor echipe de terraformare pentru a face planeta Marte complet locuibilă, se presupune că acest lucru va fi posibil peste câteva decenii.
Marte prezintă încă provocări semnificative cu lipsa unui câmp magnetic și semnificativ în atmosferă, însă Terraforming Microbiologii vor căuta soluții.
Ei vor hrăni microbii pentru a face solul pe Marte ferti și atmosfera sa mai respirabilă.
NASA va finanța o mare parte din această cercetare.
Terraforming Microbiologist: Atribuții
Microbiologii Terraforming vor fi microbiologi calificați și cu un interes deosebit pentru programe spațiale. Vor avea abilități de comunicare dezvoltate și vor trebui să ia decizii importante.